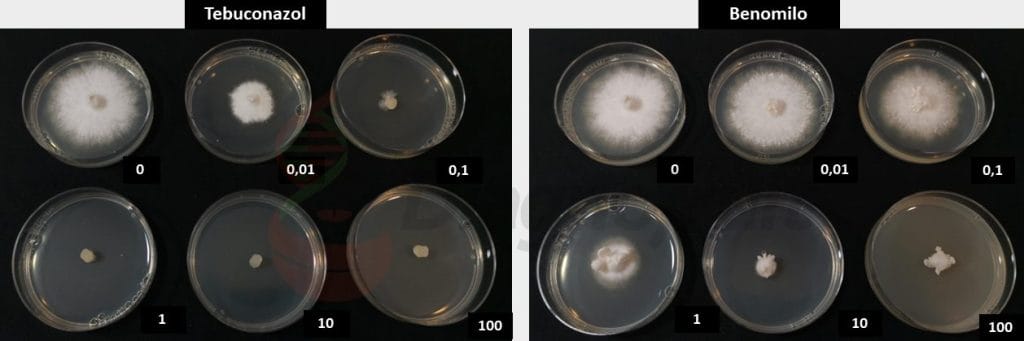

En varios artículos anteriores hemos profundizado en dos hongos que consideramos los más destructivos en cerezos en Chile, Cytospora y Calosphaeria; sin embargo, existen otras especies, que muchas veces actúan asociados con otros patógenos, que también generan pudriciones de madera, las cuales eventualmente solo deprimen la planta sin llegar a matarla, pero generan un compromiso productivo evidente, atentando contra la sostenibilidad de nuestros huertos. Dentro de estos invitados de piedra, Schyzophyllum commune es uno de los más habituales; su diagnóstico y características son muy importantes de conocer para dirigir manejos preventivos acertados y así disminuir la probabilidad de infección.
Generalmente, en los huertos de cerezos, diversos hongos Ascomicetos son nuestro motivo de control, desde Alternaria, pasando por Botrytis y Geotrichum que producen pudriciones en fruto, hasta hongos causantes de muerte de plantas como Calosphaeria y Cytospora. Sin embargo, existe otro grupo de hongos, una división llamada Basidiomycota que incluye hongos que producen basidios, una estructura productora de esporas. Esta división incluye hongos macroscópicos cómo las clásicas callampas y orejas de palo en troncos de árboles. Probablemente el conocido fitopatógeno Chondrostereum purpureum es el agente más popular de este grupo, es el organismo causante del “Plateado de los Frutales”, que causa importantes pérdidas a nivel global debido a su poder de infección de varias especies frutales. El plateado, como enfermedad, es muchas veces utilizado como término común para definir diversas afecciones de madera en campo, y dentro de esta confusión el ataque de Schyzophyllum commune es de los más confundidos y mal diagnosticados.
De acuerdo con los análisis que realizamos en laboratorio, la participación de Basidiomicetes generando pudriciones de madera de cerezos es bastante baja; C. purpureum, al menos en la zona central, es muy poco detectado, sin embargo, S.commune es de diagnóstico más común, incluso en plantas jóvenes, por lo que es muy importante aprender sus características.
Algunas características relevantes
S. commune es un hongo de dispersión global, cosmopolita, y en lugares tan distantes como México y Malasia es parte de la gastronomía local y hoy se especula sobre sus propiedades de superalimento. Es un hongo conocido no solo como causante de enfermedades en plantas, en humanos causa serios problemas en pulmones, sinusitis y más raramente infecciones cerebrales; en otras palabras, estamos ante un posible protagonista de la serie “The Last of Us”.
Desde el punto de vista fitopatológico, se describe como un hongo oportunista que vive en heridas o incluso como saprófito, pero otras definiciones lo reconocen derechamente como un hongo fitopatógeno de árboles vivos causando la llamada “Pudrición por Schizophyllum”.
Al igual que hongos como Cytospora o Calosphaeria, Schyzophyllum necesita de heridas para entrar a la madera de árboles vivos; de esta forma, poda, daño por heladas o en la vereda opuesta causadas por extrema radiación solar, lesiones causadas por otros patógenos (bacterias), ramaleo, pueden ser su punto de entrada. Su pudrición se caracteriza como “blanca”, debido al tono en madera cuando se desarrolla la infección; este efecto ocurre debido a que es un hongo “lignícola”, ya que degrada la lignina dejando tonos más claros en la madera.
Este patógeno es muy adaptado, vive sobre diversas realidades climáticas muy disímiles, y aprovecha el estrés del vegetal para consolidar su infección, considerando, además, la herida como puerta de entrada. Situaciones de estrés hídrico o manejos de poda violentos como rebajes, pueden propiciar su ataque más virulento (Foto 1).

Aunque este hongo es un débil descomponedor de madera in vitro, preferentemente invade los tejidos vivos de las plantas, incluida la corteza (Foto 2) y floema, siendo excepcional como basidiomiceto que pudre la madera, comparado con C. purpureum, por ejemplo.

¿Cómo Identificarlo?
Si bien siempre es conveniente tener un análisis de laboratorio para elaborar un diagnóstico preciso, en campo podemos observar cuerpos fructíferos característicos en troncos y ramas, vivos o muertos (Foto 2). Las superficies inferiores C. purpureum, tal como su nombre lo indica, muestran vívido color púrpura; en la otra mano, S. commune presenta estos tejidos de color marrón claro (Foto 3), características que nos permiten diferenciar en campo ambas especies.

Claves para su control
Aunque suene ya de perogrullo, siempre se debe partir con tejido vegetal sano; no pocas veces hemos observado plantaciones nuevas infectadas con este hongo, y al retroceder a las plantas madre nos damos cuenta de la presencia de Schyzophyllum. Esto muchas veces no condena las plantas en el momento, pero genera una problemática de mediano y largo plazo, atentando directamente con la sostenibilidad del huerto.
Todas las buenas prácticas de poda, partiendo con la desinfección de herramientas, evitar la poda cuando las ramas están grandes (curación más larga), promover cortes adyacentes a la rama principal pero no en ella, para generación de callos más rápidos, son todas recomendaciones que disminuyen el riesgo.
Medidas sanitarias como eliminación de cuerpos frutales y ramas muertas ayudan a sacar inóculo del campo y disminuir la probabilidad de infección.
Pintura de poda al realizar manejos, sobre todo de cortes gruesos, puede impedir el desarrollo de infecciones, pero solo si se cubre bien el corte. Para apoyar la poda, se pueden incluir aplicaciones, inmediatamente después de la labor, de fungicidas o control biológico (Trichodermas o consorcios), con el fin de bajar las probabilidades de infección, siempre actuando con una actitud preventiva.
Ensayo de sensibilidad a fungicidas
Para tener un acercamiento de qué activos podrían tener mayor actividad de control en campo, para aspersiones preventivas luego de manejos críticos como poda, realizamos un análisis de sensibilidad (Foto 4) a cuatro fungicidas de amplio espectro de uso común en cerezos, determinando EC50 hacia cada activo para cinco cepas de S. commune obtenidas de dos huertos de cerezos de la zona sur de Chile. Los resultados se pueden observar en el gráfico 1.
Dos activos, Captan y Tebuconazole, resultaron en EC50s promedio menores a 1 ppm, valores que los proyecta como candidatos de uso en campo para el manejo preventivo del patógeno. Más investigaciones se deben realizar para ajustar dosis, momentos de aplicación adecuados y también para conocer la epidemiología bajo condiciones locales, en virtud de la conocida capacidad de adaptación de Schyzophyllumcommune.